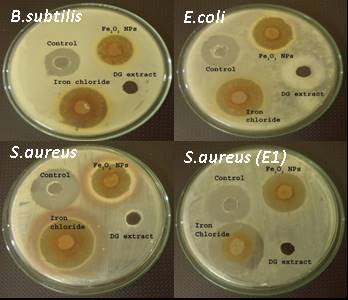

Vascular Biology Laboratory, School of Chemical and Biotechnology, SASTRA University, Thanjavur, Tamil Nadu
Email: ginokurian@hotmail.com
Received: 17 Nov 2014 Revised and Accepted: 12 Dec 2014
ABSTRACT
Objective: Synthesis, characterization and biological evaluation of iron oxide nanoparticles prepared by Desmodium gangeticum root aqueous extract.
Methods: Iron Oxide nanoparticles (FeO NPs) were synthesized by the reduction of iron chlorides using phyto-constituents as bio-reductants. The synthesis of FeO NPs was confirmed by UV-Visible spectrophotometry and the average particle size was determined by X-ray diffractometry (XRD). Morphology of the synthesized FeO NPs was identified using Scanning Electron Microscopy (SEM). Further characterization of FeO NPs was done to study its nature by FTIR and TGA. Biological activity of FeO NPs was analyzed through its free radical scavenging activity and antimicrobial effect. Further, cytotoxicity was examined against LLC-PK1 cell lines using LDH assay.
Results: Thus synthesized particles exhibit rhombohedra crystalline phase. Morphology was identified as spherical and particle size ranges from 25 to 35 nm in diameter with an average size of 30 nm analyzed from SEM micrograph. FeO NPs showed a comparable antimicrobial activity as that of control drug (ciprofloxacin) towards Gram positive bacteria. Iron oxide nanoparticles were also found to be non-toxic by the LDH assay
Conclusion: Green synthesis of Fe nanoparticles using Desmodium gangeticum root aqueous extract was considered to be relatively safe and particles possesses significant biological activity.
Keywords: Desmodium gangeticum, FeO Nanoparticles, LLC-PK1 cell line, Antimicrobial agent, Antioxidant, Cytotoxicity.
INTRODUCTION
Recently, nanotechnology received greater attention due to its huge ability to fabricate, characterize and specifically tailoring the functional properties suitable for biomedical applications and diagnostics [1]. Several well-characterized bulk materials have been found to possess the most interesting properties when studied in nanoscale [2]. Iron nanoparticles were studied extensively in the field of medical imaging; magnetic storage, hyperthermia [3], drug delivery, cellular therapy.
Generally, synthesis of iron oxide nanoparticles involves physical routes such as photolytic reduction [4], thermal decomposition [5] and chemical methods such as co-precipitation [6], micro emulsions [7]. Nanoparticles with less toxic nature are the major requirement in the recent research and biosynthetic methods involving fungi [8], bacteria [9] and plants [10] were widely reported. Biologically active compounds present in microbes or plants can act both as reducing and stabilizing agent, thereby not only able to synthesize NP, but also a product with less toxicity or non-toxic.
Desmodium gangeticum (Fabaceae family) (DG) is a small shrub found in tropical countries, which is widely used in the indigenous system of medicine [11] and also reported containing flavones and iso-flavonoid glycosides [12]. Alkaloids, terocarpnoid, flavonoid, saponins and iso-flavonoid glycoside were in the extract and report having high reducing property [13]. DG extract have been widely used in many therapeutic Ayurveda preparations and also plays a significant role in inflammation [14], ischemia reperfusion injury [15] and myocardial infarction [16].
In this manuscript, we carried out biosynthetic approach to prepare FeO NPs from the solution of Iron chlorides using aqueous extract of Desmodium gangeticum root at optimum temperature without any surfactant and an inert gas atmosphere. Synthesized nanoparticles were then further characterized for their size, morphology and its chemical environment. Moreover, its cytotoxicity was examined in LLC-PK1 cell line, and the biological activity was assessed by measuring its antioxidant potential and antimicrobial action.
MATERIALS AND METHODS
Materials
Iron (III) chloride (FeCl3), Iron (II) chloride (FeCl2); aqueous DG extract, DPPH (2, 2-diphenyl-1-picrylhydrazyl), Nitroblue tetrazolium, Folin-Ciocalteu (FC) reagent, Sodium carbonate (Na2CO3), Potassium hexacyanoferrate (Na4Fe(CN)6), Trichloroacetic acid (TCA), ethanol were purchased from Sigma Aldrich, India. Mueller Hinton Agar, Agar from Hi Media. LLC-PK1 cell line was purchased from NCCS Pune, India. All chemicals were used as such without any further purification.
Preparation of aqueous DG extract
Roots of Desmodium gangeticum (Linn) DC were collected from St. Berchmans College Botanical garden, Changanassery, Kerala, India and were authenticated by HOD, Botany Department, SB College. The voucher of the specimen was kept for reference. Dried roots were washed thrice thoroughly with tap water and dried in the shade. Dried roots were cut into small pieces and ground coarsely using pulverizer. Coarse root powder was extracted using distilled water in Soxhelt apparatus. Thus obtained crude extracts was dried, lyophilized and powder was refrigerated for further use.
Synthesis of Iron oxide nanoparticles
FeO NPs was prepared by reducing iron chlorides using aqueous DG extract. 10 mM FeCl3 and FeCl2 mixture were added with aqueous DG extract (1:2 w/v ratio) and stirred for complete dissolution. The solution was then heated at 80 °C under continuous stirring for 30 minutes until it turns to black color [10]. Then, the particles were dried, and further characterization was carried out.
Characterization of Iron oxide nanoparticles
UV-visible spectroscopy
Preliminary characterization of FeO NPs was carried out using an UV-visible spectrophotometer. Nanoparticles were analyzed for its characteristic maximum λ peak and spectra were obtained in the wavelength range between 300 nm and 800 nm.
Fourier transform infrared spectroscopy (FTIR)
FTIR spectral analysis was carried out in the Perkin Elmer spectrum 1 in diffuse reflection mode operating at a resolution of 4 cm-1. FTIR spectroscopy was performed to identify the functional groups and chemical environment around the synthesized nanoparticles. The dried FeO NPs was finally grounded with KBr in the ratio 1:300 and it is palletized using mechanical, hydraulic apparatus. The pellet was kept in the sample holder, and the spectrum was recorded between 4000 and 400 cm-1.
X-ray diffractometry (XRD)
XRD is the mostly used technique to analyze the amorphous/crystalline nature of the nanoparticles along with its phase and purity of the sample. XRD pattern of finely ground FeO NPs was recorded in a wide range of Bragg’s angle (θ) from 10 to 80 at a scanning rate of 2° min−1. Measurement was carried out with Rigako instrument, operated at 40kV voltage and 30mA current with CuKα radiation (1.5405 Å). The average particle size was calculated by using Debye Scherrer formula as given in equation 1
Where, λ (lambda) is the wavelength of X-ray (0.1541 nm), β is FWHM (full width at half maximum), θ is the diffraction angle and ‘D’ is particle diameter.
Scanning electron microscopy
The size and morphology of FeO NPs were studied using scanning electron microscopy (SEM). A thin film of iron nanoparticles was prepared on carbon coated copper SEM grids, extra sample solutions were removed by blotting paper after allowing the sample to stand for 5 minutes. The SEM images were recorded (JEOL-JSM 7601F, Japan) at 40, 000X magnification operating with a 3keVelectron beam at a working distance approximately 7 mm.
Thermo gravimetric analysis
Thermal stability of the nanoparticles was determined from thermal spectra. A suitable amount of nanoparticles was taken, and spectra were recorded under a nitrogen atmosphere at a heating rate of 10ᵒC/min from room temperature up to 1000ᵒC using the SDT-Q600 model, TA Instrument, USA.
DPPH, total phenol and reducing power assay
DPPH is a stable organic radical. The capacity of biological materials to scavenge DPPH radical is expressed as its antioxidant ability. DPPH assay was carried out by Solver-Rivas et al. (2000) protocol, with some modification. The synthesized FeO NPs was taken in different concentrations using serial dilution (1000µg-31.5 µg) with ethanol. 10 µl of the FeO NPswas added to 150 µl of an ethanolic solution of 0.3 mm DPPH followed by the addition of 140 µl of ethanol. The mixture was allowed for 30 minutes incubation at room temperature in the dark. After incubation, the absorbance was measured at 518 nm. The scavenging of DDPH was calculated as follows:
In this assay for the determination of total phenolic compounds [17], 1 ml of FeO NPs (1 mg/ml in phosphate buffer) was taken and added to 1 mL of 1:10 diluted Folin-Ciocalteu reagent. The mixture is kept for incubation at room temperature for 5 minutes. After incubation, 4 mL of 1M Na2CO3 was added and kept for 15 minutes incubation. The absorbance was measured at 765 nm. The standard taken in this assay was ascorbic acid at various dilutions (1000µg-31.5 µg) for calibrating the curve.
Reducing power of FeO NPs was determined by Oyaizu (1856) method with slight modification. 0.75 mg FeO NPs was taken and was added to 0.75 mL of 0.2M (pH 6.6) phosphate buffer, followed by the addition of 0.75 mL of 1% potassium hexacyanoferrate. The mixture was incubated at 50 °C in the water bath for 20 minutes. 0.7 mL of 10% TCA solution was added to the mixture to stop the reaction. The content was then centrifuged (1500rpm) for 10 minutes and 1.5 mL of supernatant were taken. To this, a mixture of 1.5 mL of distilled water and 0.1 mL of 0.1% FeCl3 was added and allowed for 10 minutes incubation. The absorbance was measured at 700 nm.
Antimicrobial assay
Agar well diffusion method was followed (Murray et al., 1995) to determine the antimicrobial activity of the synthesized FeO NPss. Strains viz., Bacillus subtilis (MTCC-2413), Escherichia coli (MTCC-573), Staphylococcus aureus (MTCC-3160) and Staphylococcus aureus (E1-Env. Isolate) were used. Muller Hinton agar plates were prepared and swabbed with the broth culture of the respective bacteria. Four wells were bored in each plate with a sterile cork borer. Stock solutions of FeO NPs, ciprofloxacin (control), pure DG extract, iron chlorides (precursor) were prepared at a concentration of 1 mg/ml in distilled water. 100 µl of these samples was added to each well. The plates were incubated at 37 °C for 24 hrs after which the diameter of the zone of inhibition was measured.
Toxicology
Cytotoxicity of FeO NPs was determined by lactate dehydrogenase activity (LDH) in the culture medium. This assay determines the release of cytoplasmic enzyme lactate dehydrogenase to the culture media due to its leakage from the damaged cells in the presence of the nanoparticles. Cells were seeded in 96 well plates and were treated with synthesized Fe Nanoparticle, along with the precursor separately. After 24 hrs of treatment, a small aliquot of the medium was collected and incubated with a reaction mixture containing NAD+, lactate and phosphate buffer (0.2M, pH 7.4), each 50 µl. The LDH catalyzed conversion results in the reduction of NAD+to NADH, which was measured at an absorbance of 340 nm. LDH activity was calculated using the formula,
Where AT is the absorbance at time ‘T’.
Statistical analysis
In the biological evaluation assays like DPPH, reducing potential, total phenol and cytotoxicity, the data signify the mean±SD of three samples and are representatives of three independent experiments. The data were subjected to analysis of variance (ANOVA) by graph pad prism 5.
RESULTS AND DISCUSSION
Physico-chemical characterization of Iron oxide nanoparticles
Optical Properties
Surface plasma resonance exhibited by FeO NPs was measured with the absorption spectra by using a Double Beam UV–vis spectrophotometer shown in (Fig.1A). UV–vis spectral analysis of FeO NPs gave broad surface plasmon resonance spectra at 303 nm[18], which indicated the presence of FeO NPs and physically verified by the color changes from brown to black. The shift in peak from the reference range may be due to the reduced size of the synthesized nanoparticles. Many of the distinctive colors of nanoparticle colloids may be attributed to the presence of this surface plasmon absorption band. The oscillation of free electron confined to the surface, responsible for SPR, is sensitive to changes in the size of the particle and increase the energy required to collectively excite motion of the surface plasmon electrons.
X-ray Diffractometry (XRD)
X-ray diffraction patterns have been widely used in nanoparticle research to characterize critical features such as a crystal structure, crystallite size, and strain. The XRD pattern of FeO NPs is shown in (Fig.1B). Sharp diffraction peak emerges at 2θ angles of 24.2 °, 32.2 °, 54.1 °, 40.9 °, 49.5 °, 57.3 °, 62.5 ° and 64.0 ° correspond to the hkl values from (012), (104), (116), (113), (024), (122), (214), (300) crystal planes respectively (JCPDF # 089-2810) representing rhombohedral crystalline phase [19] of Fe2O3. From the maximum intensity peak, average particle diameter was found to be around 6 nm.
Fourier transform infrared spectroscopy (FTIR)
FTIR analysis was performed to identify the interaction between different species and changes in chemical composition of the mixture. (Fig.1C) shows the IR spectra of FeO NPs recorded between 400-4000 cm-1. The broad peaks at 3399.98 cm-1, 1630.09 cm-1, 1404.49 cm-1, 1063.80 cm-1, 680.49 cm-1refersto O-H stretch, alkenyl C=C stretch, carboxyl groups, C-O stretching vibration and alkene C-H bend respectively. The formation ofFe2O3 nanoparticles is characterized by the peak at 571.14 cm-1 that correspond to Fe-O stretching bond [20]. FTIR analysis of DG root extract (Fig.1D) shows peaks at 3404.83 cm-1, 2928.63 cm-1, 1622.95 cm-1, 1404 cm-1corresponding to O-H stretch, alkenyl C=C stretch, carboxyl groups, C-O stretching vibration and alkene C-H bending respectively. The comparative analysis shows the association of biomolecules of DG extract in the synthesized FeO NPs.

Fig. 1: Characterization of FeO NPs by UV, XRD, FTIR (A) UV-Visible spectrum of FeO NPs were measured at a range of 300-800 nm and showed broad peak at 303 nm (B) X-Ray Diffractometry of FeO NPs (C) Fourier Transform Infrared Spectroscopy of FeO NPs (Perkin Elmer spectrum 1) (D) Fourier Transform Infrared Spectroscopy of DG root extract

Fig. 2: Scanning Electron Micrograph (JEOL-JSM 7601F, Japan) of FeO NPs showing spherical surface morphology
Scanning Electron Microscopy (SEM)
Scanning electron microscopy was used to characterize the mean particle size and morphology of FeO NPs. (Fig.2), shows that the synthesized FeO NPs are spherical in shape with less aggregation and confirming that the particles obtained were indeed in the nanometer range. The particle size ranges from 25 to 35 nm in diameter with an average size of 30 nm.
Thermo Gravimetric Analysis (TGA)
TGA is commonly used to determine selected characteristics of materials that exhibit either mass loss or gain due to decomposition, oxidation, or loss of volatile compounds. The physicochemical interaction in FeO NPs with bio-molecules present in DG extract was further analyzed by thermo gravimetric method. The existence of physicochemical moisture either in the form of physical adsorption or in the chemically bound hydroxyl group was determined in this procedure.
The decomposition temperature measured for FeO NPs suggests multiple stage decomposition, where nanoparticles were relatively stable for around 600 °C after an initial loss of weight (11%) at 80 °C (fig. 3B). On the other hand, DG extracts showed single stage decomposition between 80 °C-600 °C (fig. 3A), maybe due to different chemical reactions like loss of water of crystallization, combustion and physical transition like vaporization, evaporation, sublimation and drying.
In case of green synthesized FeO NPs, the thermal labile compounds (up to 600ᵒC) may be associated with the nanoparticles and provide stability to the biologically prepared nanoparticles. The different biomolecules like gangetin, phenethylamine, β-amyrone, tryptamine reported in DG extracts [21] may be in association with the FeO NPs as their melting points are within 600ᵒC. Further confirmation was done with FT-IR, where some of the IR peaks correspond to the spectrum of an above compounds and support the fact that the compounds from DG extract are strongly associated with the nanoparticles.

Fig. 3: Thermo Gravimetric Analysis (A) TGA of DG shows single stage decomposition of DG biomolecules decomposed between 80 °C-600 °C (B) TGA of FeO NPs showing multiple stage decomposition, where nanoparticles were relatively stable for around 600 °C after an initial loss of weight at 80 °C
Fig. 4: Antimicrobial assay of FeO NPs. The figs shows antimicrobial activity of FeO NPs, Control (ciprofloxacin), Precursor (Iron chloride) and DG extract
Antimicrobial assay
Antimicrobial activity of FeO NPs determined by agar well diffusion method, against Gram negative (E. coli) and Gram positive bacteria (S. aureus, B. subtilis) are shown in (fig. 4). The zone of inhibition was measured using the software Image J (National Institutes of Health) and the values are tabulated as in Table1. Compared to the precursor, FeO NPs showed relatively low antimicrobial activity, however, with respect to DG extracts, antimicrobial activity of the nanoparticles was significantly high. Furthermore, It was postulated that bacteria can absorb Fe3+and reduce Fe3+to Fe2+. The bacteriostatic effect of iron is directly proportional to the iron concentration and mediate inhibition through hydroxyl free radicals [22].
Total phenol content, Reducing potential, DPPH
The Folin–Ciocalteau method was used to determine the total phenolic content [23]. Generally, high reduction potential and excellent antioxidant properties are characteristics of phenolic compounds (fig. 5A). These properties depend on the structure number and positions of the hydroxyl groups and the nature of substitutions on the aromatic rings present in the sample. Our results indicate relatively low phenol content in FeO NPs, 0.34 mg/ml of ascorbic acid equivalent. Relatively low reduction potential, as compared to DG extract was observed (fig. 5B). However, the DPPH results (fig. 6) suggest that it can mediate potent scavenging activity (40% DPPH radical scavenging at concentration 0.03125 mg/ml). This may be due to the presence of phenolic and non-phenolic groups in association with the nanoparticles that are responsible for the scavenging activity.

Fig. 5: Total phenol content and reducing the potential of FeO NPs (A) The graph showed very less phenol content in FeO NPs compared to DG extract. The results were expressed as mean SD of n=4-6 independent assays, p<0.05, statistically different from the normal control group. (B) Graph shows the reducing potential of FeO NPs, Precursor (Iron chloride) and DG extract. The results were expressed as mean SD of n=4-6 independent assays, p<0.05, statistically different from the normal control group
Table 1: Antimicrobial activity, the zone of inhibition of Iron chloride (Precursor), FeO NPs, Control (Ciprofloxacin) against B. subtilis, S. aureus, E. coli, S. aureus E1, measured by using Image J 1.34s software
| Strains | Iron chloride (In mm) |
FeO NPs (in mm) | Control (In mm) |
DG (in mm) |
| Bacillus subtilis (2413) | 26.095 | 19.900 | 20.444 | 11.488 |
| Escherichia coli (574) | 26.446 | 22.068 | 35.224 | 10.407 |
Staphylococcus aureus MTCC (3160) |
28.827 | 24.156 | 22.447 | 10.076 |
| Staphylococcus aureusE1 (9886) | 41.724 | 33.556 | 27.395 | 10.038 |

Fig. 6: DPPH scavenging assay
Different doses of FeO NPs (1-0.3125 mg/ml) were treated with DPPH and the values were expressed as % scavenging ability, calculated by using the equation.
Toxicology study
The toxicity of FeO NPs in LLC-PK1 cell line was assessed by LDH based cytotoxicity assay. Upon damage of the plasma membrane, lactate dehydrogenase (LDH), a stable cytoplasmic enzyme present in all cells will be released into the cell culture supernatant and will be measured to calculate the injury index (fig. 7). Incubation of LLC PK1 cells (80% confluent, in 96 well plates) with FeO NPs for 24 hrs showed relatively very less damage to the cell as compared to the precursor or even DG extract itself, measured by LDH activity.

Fig. 7: LDH activity in culture medium of LLC-PK1 cells
The above bar graph shows LDH activity of untreated cells, Iron chloride, DG extract, FeO NPs. Treatments were made once the seeded cells reached 80% confluence. The results are expressed as mean SD of n=4-6 independent assays, p<0.05, statistically different from the normal control group
CONCLUSION
Our study presents a non-toxic, eco-friendly, economical method for the synthesis of FeO NPs using aqueous root extract of Desmodium gangeticum. The average particle size diameter of 10 nm and rhombohedral structure of the FeO NPs was confirmed by XRD analysis. FTIR studies showed the strong association of compounds of DG with the nanoparticles. Moreover, biosynthesized FeO NPs was thermally stable and proved to be a good antimicrobial agent. The significant antioxidant activity and less toxicity suggest that the FeO NPs could be a potential candidate for various biomedical applications.
ACKNOWLEDGEMENT
The authors are pleased to acknowledge SASTRA University, Thanjavur for their financial support. The authors also thank Dr. P. Brindha, Dean, CARISM (Centre for Advanced Research in Indian Systems of Medicine), SASTRA for providing research facilities.
CONFLICT OF INTERESTS
Declared None
REFERENCES